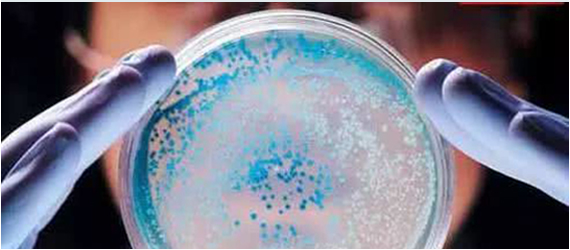

為進一步做好非洲豬瘟防控工作,降低生豬屠宰以及生豬產品流通環節病毒擴散風險,切實保障生豬產業健康發展,根據《中華人民共和國動物防疫法》《重大動物疫情應急條例》《生豬屠宰管理條例》等法律法規及有關規定,在非洲豬瘟防控期間,全面開展生豬屠宰及生豬產品流通等環節非洲豬瘟檢測。
檢測為陰性的,有關生豬產品可按照規定在本省或跨省銷售。

鎖定每一個信號,反應全程釋放出的信號記錄在案,以實現客觀的判斷。

無需跑膠,避免交叉污染。

彩色觸摸屏幕操作,僅四個步驟,檢測結果易讀明了。

單次實驗可檢測1-14個樣品,最多同時檢測5個項目。

最快20分鐘可以判斷陽性結果,60分鐘以內判斷陰陽性結果。

本機即可實現數據存儲,查詢,分析統計等功能,也可以連接電腦使用,配套專業檢測分析軟件。
 儀器操作系統,給您最舒適的操作體驗。僅四個步驟,檢測結果易讀明了。
儀器操作系統,給您最舒適的操作體驗。僅四個步驟,檢測結果易讀明了。
1.核酸抽提


2.試劑準備


3.上機反應


4.結果判讀